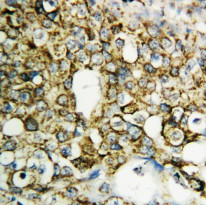

ARG40986
anti-TFPI2 antibody
anti-TFPI2 antibody for IHC-Formalin-fixed paraffin-embedded sections,Western blot and Human
Overview
| Product Description | Rabbit Polyclonal antibody recognizes TFPI2 |
|---|---|
| Tested Reactivity | Hu |
| Tested Application | IHC-P, WB |
| Host | Rabbit |
| Clonality | Polyclonal |
| Isotype | IgG |
| Target Name | TFPI2 |
| Antigen Species | Human |
| Immunogen | Synthetic peptide corresponding to aa. 170-186 of Human TFPI2 (NVTRYYFNPRYRTCDAF). |
| Conjugation | Un-conjugated |
| Alternate Names | REF1; TFPI-2; Placental protein 5; PP5; Tissue factor pathway inhibitor 2 |
Application Instructions
| Application Suggestion |
|
||||||
|---|---|---|---|---|---|---|---|
| Application Note | * The dilutions indicate recommended starting dilutions and the optimal dilutions or concentrations should be determined by the scientist. |
Properties
| Form | Liquid |
|---|---|
| Purification | Affinity purification with immunogen. |
| Buffer | 0.2% Na2HPO4, 0.9% NaCl, 0.05% Thimerosal, 0.05% Sodium azide and 5% BSA. |
| Preservative | 0.05% Thimerosal and 0.05% Sodium azide |
| Stabilizer | 5% BSA |
| Concentration | 0.5 mg/ml |
| Storage Instruction | For continuous use, store undiluted antibody at 2-8°C for up to a week. For long-term storage, aliquot and store at -20°C or below. Storage in frost free freezers is not recommended. Avoid repeated freeze/thaw cycles. Suggest spin the vial prior to opening. The antibody solution should be gently mixed before use. |
| Note | For laboratory research only, not for drug, diagnostic or other use. |
Bioinformation
| Database Links | |
|---|---|
| Gene Symbol | TFPI2 |
| Gene Full Name | tissue factor pathway inhibitor 2 |
| Background | This gene encodes a member of the Kunitz-type serine proteinase inhibitor family. The protein can inhibit a variety of serine proteases including factor VIIa/tissue factor, factor Xa, plasmin, trypsin, chymotryspin and plasma kallikrein. This gene has been identified as a tumor suppressor gene in several types of cancer. Alternative splicing results in multiple transcript variants. [provided by RefSeq, Aug 2012] |
| Function | May play a role in the regulation of plasmin-mediated matrix remodeling. Inhibits trypsin, plasmin, factor VIIa/tissue factor and weakly factor Xa. Has no effect on thrombin. [UniProt] |
| Cellular Localization | Secreted. [UniProt] |
| Calculated MW | 27 kDa |
Images (2) Click the Picture to Zoom In
-
ARG40986 anti-TFPI2 antibody IHC-P image
Immunohistochemistry: Paraffin-embedded Human mammary cancer tissue stained with ARG40986 anti-TFPI2 antibody.
-
ARG40986 anti-TFPI2 antibody WB image
Western blot: MDA-MB-453, MDA-MB-231, HeLa, HT1080 and Jurkat cell lysates stained with ARG40986 anti-TFPI2 antibody.